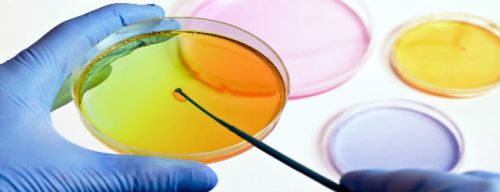

Разновидности анализов
Существуют различные методы диагностики. Например, инвазивный тест включает забор не менее пяти образцов слизистой оболочки желудка из разных участков. Этот метод применяется в сложных случаях после лечения инфекции и считается экспертным. Однако мы сосредоточимся на неинвазивных тестах, которые чаще используются в лабораторных исследованиях.
К ним относятся:
- серологический анализ — исследование крови на наличие хеликобактер пилори,
- современный дыхательный тест,
- ПЦР-диагностика и обнаружение антигена.
Рассмотрим эти методы подробнее.
Уреазный тест
Этот метод диагностики является современным и эффективным. Он точен, чувствителен и специфичен. В гастроэнтерологии это исследование первой линии, так как оно позволяет диагностировать инфекцию и подтвердить её излечение.
Лечение хеликобактерной инфекции называется эрадикацией, что в переводе с латинского означает «искоренение».
Для расщепления соляной кислоты и создания благоприятных условий для микроорганизмов вырабатывается фермент уреаза. Основным субстратом для этого фермента является мочевина. Тест основан на использовании мочевины, которая «предлагается» микробам для переработки в аммиак. Однако в этой мочевине обычный атом углерода заменён на изотоп, содержащий один лишний нейтрон, что увеличивает атомную массу на единицу (С-13). Если у пациента есть хеликобактер, микробы из меченой мочевины выработают меченый аммиак. В выдыхаемом воздухе можно будет обнаружить углекислый газ с атомами изотопа мочевины. Этот метод основан на том, что только хеликобактер пилори может переработать мочевину в аммиак.
Исследование кала
Хеликобактер пилори выделяется с калом в устойчивых формах, что позволяет использовать два современных метода диагностики: обнаружение бактериального антигена в кале и идентификацию наследственного материала возбудителя с помощью ПЦР (полимеразной цепной реакции).
Эти методы удобны для пациента, но считаются вспомогательными. Наилучшим способом остается выделение микроорганизма непосредственно из его обитания.
Анализ крови
В настоящее время популярно определять инфекции по анализу крови, в том числе хеликобактерную инфекцию. Однако в крови не обнаруживается сам микроб или его антигены, а выявляются антитела к Helicobacter pylori, что отражает иммунный ответ организма.
Серологические методы исследования позволяют обнаруживать иммуноглобулины разных классов как в качественном, так и в количественном выражении. Эти тесты особенно важны при подозрении на первичную инфекцию. Например, если к гастроэнтерологу обращается пациент с первыми признаками диспепсии — вздутием живота, отрыжкой, тошнотой и дискомфортом в эпигастрии.
Высокий титр специфических антител может указывать на активный процесс, но анализ крови не поможет определить его причину. Также не следует использовать анализ крови для подтверждения излечения от инфекции, так как титр антител может оставаться высоким до двух лет после выздоровления. Поэтому серологические исследования Helicobacter pylori, как и анализы кала, являются вспомогательными.
Тест показан, если биопсия желудка невозможна, например, при пониженной свертываемости крови. Однако при слабом иммунном ответе антитела могут выделяться в незначительном количестве и не быть обнаружены, что приведет к ложноотрицательному результату.
Для более точной диагностики наличия или отсутствия Helicobacter pylori рекомендуется использовать комбинацию различных исследований. Какой анализ сдать и какие показания к описанным методам, следует уточнить у врача.
Какие анализы нужно сдать на хеликобактер пилори
В настоящее время существует множество способов обнаружения бактерий, их продуктов жизнедеятельности и антител к ним. Каждый метод имеет свои достоинства и недостатки.
Пациентам рекомендуется сдавать несколько анализов для подтверждения наличия микроба. Врач подберет необходимые исследования, учитывая конкретный клинический случай и техническую оснащенность медицинского учреждения.
Каждому пациенту необходимо пройти ФГДС с биопсией. Изучение биоптата слизистой может проводиться с помощью микроскопии, экспресс-тестов или культивирования бактерий на питательных средах.
Также полезно сдать кровь и кал для серологической диагностики. Высокий титр антител к бактерии или её ДНК-фрагменты в испражнениях могут подтвердить инфекцию.
Дыхательный тест — это неинвазивный способ, который позволяет достоверно подтвердить наличие бактерии и её активность. Если есть возможность пройти его в медицинском учреждении, стоит воспользоваться этой услугой.
Анализы на хеликобактерную инфекцию сдаются не только для выявления микроорганизма, но и для контроля излеченности. Необходимые исследования определяет врач.
Какой анализ на хеликобактер пилори самый информативный
Точными методами анализа являются:
- Цитологический метод — наблюдение бактерий под микроскопом.
- Культуральный метод — выращивание бактерий на питательных средах.
- Метод ПЦР-диагностики — обнаружение генов или ДНК-фрагментов бактерий.
Все эти методы требуют предварительного взятия биоптата — кусочка слизистой желудка при проведении ФГДС. Они инвазивны и невозможны без эндоскопии.
В отличие от серологических методов, которые выявляют антитела и косвенно указывают на наличие микроба, или ферментных методов, диагностирующих продукты жизнедеятельности бактерий, цитология позволяет обнаружить патогена непосредственно.
Мазки высушиваются, окрашиваются специальными красителями и изучаются под микроскопом. Бактерии имеют S-образную или спиралевидную форму и жгутики на конце. Опытный врач-диагност без труда распознает эти микроорганизмы.
Культуральный метод позволяет вырастить колонию бактерий на питательных средах с низким содержанием кислорода (не более 5%). Для этого используют кровяные питательные среды.
При соблюдении температурного режима и анаэробных условий через 3-5 суток на среде появляются круглые, прозрачные колонии бактерий, которые затем идентифицируют.
ПЦР-методы обнаружения генов и фрагментов ДНК хеликобактеров информативны, но требуют специального оборудования и реактивов, которые есть не во всех поликлиниках.
Врачи рекомендуют для выявления H. pylori использовать три, а лучше четыре метода диагностики: цитологический, культуральный, ПЦР и дыхательный тест.
Какой анализ лучше всего сдать на хеликобактер
Перечень анализов определяет врач с учетом конкретного случая и цели исследования.
С профилактической целью, при отсутствии жалоб со стороны органов ЖКТ, можно использовать неинвазивные методы диагностики (без ФГДС):
- анализ крови для серологического выявления антител к микробу;
- анализ кала для ПЦР-диагностики фрагментов ДНК;
- дыхательный тест.
Неинвазивные методы также рекомендованы после лечения для оценки его эффективности, а также ослабленным и тяжелобольным пациентам, которым нельзя проводить инвазивные процедуры.
Если есть жалобы со стороны органов ЖКТ или подозрения на инфицирование, необходимо провести ФГДС с последующим взятием образца слизистой желудка. В этом случае рекомендуются цитологический, культуральный, уреазный экспресс-тест или ПЦР-диагностика биоптата.
Не существует «золотого стандарта» диагностики микроба. Все методы дополняют друг друга, поэтому следует использовать несколько из них. Выбор и тактика диагностики остаются прерогативой лечащего врача.
Подготовка
Подготовка к анализу венозной крови на антитела и определение антигена в кале не требует специальных мер. Однако для повышения точности ПЦР на хеликобактер необходимо провести предварительную подготовку.
Если вам назначили ПЦР на хеликобактер, выполните следующие рекомендации:
- Исключите прием антибиотиков и антибактериальных препаратов. Это может потребовать переноса анализа или отмены антибиотиков за несколько дней.
- Откажитесь от слабительных, не используйте ректальные свечи и временно прекратите прием препаратов, влияющих на перистальтику кишечника, таких как спазмолитики, Беллатаминал и пилокарпин (применяемый в каплях для лечения глаукомы).
Сообщите врачу обо всех принимаемых препаратах после назначения исследования.
Подготовка к уреазному тесту требует особого внимания. Как правильно подготовиться к этому анализу?
Уреазный тест: подготовка и проведение
Врач предупреждает пациента о следующих условиях перед уреазным тестом:
- Тест можно проводить не ранее чем через полтора месяца после приема антибиотиков или препаратов, содержащих висмут, например, Де-нол.
- За 14 дней до теста следует отказаться от лекарств для лечения язвенной болезни, таких как ингибиторы протонного насоса (например, Омепразол) и антагонисты гистаминовых рецепторов (например, Фамотидин, Ранитидин).
- За три дня до исследования необходимо исключить алкоголь.
- Если пациент недавно прошел фиброгастроскопию, тест можно делать не ранее чем через сутки после процедуры.
- За 6 часов до теста нельзя есть. Воду можно пить, но только негазированную и чистую.
Таким образом, подготовка к уреазному тесту должна начинаться за полтора месяца до его проведения.
Схема тестирования следующая:
Две пробы проверяются на специальном оборудовании. Исследуется количество изотопа углерода (С13) и обычного углерода (С12) в выдыхаемом воздухе. Если в желудке есть инфекция хеликобактером, во второй пробе концентрация С13 будет выше, чем в первой.
Тест прост, доступен и комфортен. Он обладает высокой чувствительностью и специфичностью, что обуславливает его стоимость — в среднем 2200 рублей.
Анализ кала на хеликобактер пилори: как его правильно сдавать?
Анализ кала на хеликобактер пилори — надежный способ выявления этой бактерии, которая вызывает язвы и другие заболевания пищеварительного тракта. Анализ считается прямым доказательством наличия хеликобактера, если обнаруживаются либо сами бактерии, либо их ДНК. Достоверность этого анализа является одной из самых высоких.
Методики анализа и расшифровки показателей
Биологический материал можно исследовать различными методами.
| Метод | Сроки проведения | Расшифровка результатов |
|---|---|---|
| ПЦР | 1 рабочий день | * отрицательно; * положительно |
| Бакпосев | от 6 до 12 дней | * не обнаружено; * 1 степень – нет роста на твердой среде; * 2 степень – 10 колоний; * 3 степень – до 100 колоний; * 4 степень – более 100 колоний |
| ИФА | Венозная кровь, в течение рабочего дня, срочно за 2 часа | * положительно – 1,1 Ед/мл, высокий риск; * сомнительно – от 0,9 до 1,1 Ед/мл, рекомендуется повтор через 2 недели; * отрицательно – ниже 0,9 Ед/мл, низкий риск |
Другие способы выявления хеликобактера
При обследовании для выявления хеликобактера используют несколько методов:
- Дыхательный тест. Пациент выдыхает в мешочек, затем выпивает радиоактивный углерод. Через 10 или 30 минут снова выдыхает в другой мешочек. Этот тест позволяет обнаружить хеликобактера даже в малых количествах.
- Быстрый уреазный тест желудочного биоптата. Бактерия выделяет уреазу, которая расщепляет мочевину на аммиак и углекислый газ. Во время эндоскопии берут 4 биоптата из разных участков желудка и помещают их в ячейки CLO-теста. Чем больше хеликобактера, тем быстрее меняется цвет ячейки.
- Антиген хеликобактера в кале. Частицы бактериальной стенки реагируют с моноклональными антителами, что изменяет цвет индикатора. Для домашнего использования доступны тест-кассеты. По инструкции кал смешивают с растворителем, несколько капель наносят в окно кассеты. Две полоски означают положительный результат, одна — отрицательный. Также можно проверить действительность теста по маркировке.
- Гистологическое исследование биоптата. Полученный при ФГДС биоптат (5 образцов) окрашивают по различным методикам. Чувствительность анализа достигает 99%.
- Вестерн-блот. Этот метод применяют для определения антител к хеликобактеру, выявленных с помощью ИФА. Определяется количество антител каждого класса (A, G, M).
Выбор диагностических тестов зависит от оснащенности лечебного учреждения. «Золотым стандартом» считается гистологическое исследование. Однако положительный результат хотя бы двух разных тестов достаточно для подтверждения наличия бактерии.
Что делать при положительном анализе?
Необходимо как можно скорее посетить гастроэнтеролога для определения необходимости эрадикации (удаления) бактерии. Этот процесс имеет свои нюансы и противопоказания, поэтому консультация врача обязательна.
После оценки состояния здоровья врач выбирает одну из международно утвержденных схем лечения. В зависимости от особенностей заболевания используются комбинации препаратов из следующих групп:
- ингибиторы протонной помпы – Омепразол, Рабепразол и другие;
- кларитромицин – антибиотик группы макролидов;
- амоксициллин – полусинтетический пенициллин;
- метронидазол – противопротозойный препарат с антибактериальной активностью;
- препараты висмута – противоязвенные, защищающие слизистую желудка;
- тетрациклин – антибиотик широкого спектра действия.
В процессе лечения тесты на хеликобактер могут повторяться для оценки эффективности терапии.
После удаления бактерии язвы и другие поражения слизистой заживают, восстанавливаются микрофлора, синтез витаминов и гормонов, нормализуется пищеварение, а риск развития рака желудка снижается.
Норма анализа
Перед анализом исключите алкоголь, физические нагрузки и жареную пищу. Биологический материал сдавайте натощак, допускается небольшое количество воды.
Ограничения:
Биоматериал собирайте в пластиковый контейнер, который можно купить в аптеке. Наполните его на 1/3. Забирайте кал только из контейнера, так как в унитаз могут попасть моющие средства, и это исказит результаты анализа.
На заметку!
Кал необходимо быстро доставить в лабораторию. Максимальный срок хранения — 10-12 часов при температуре от -8 до -2 °C.
Анализ крови безопасен и имеет минимум противопоказаний:
- Судорожные состояния.
- Перевозбуждение пациента.
- Травмы кожи в области укола.
- Флебит вены, из которой берется кровь.
Уровень антител определяется по цвету. Результаты анализа могут быть количественными или качественными в зависимости от типа исследования. Анализ кала показывает только наличие или отсутствие инфекции. ИФА точно определяет наличие специфических антител к Helicobacter pylori, а Вестерн-блот измеряет их титр.
Нормы Helicobacter pylori могут варьироваться в зависимости от используемого оборудования, так как его чувствительность и диагностические показатели различаются. Расшифровку результатов должен проводить специалист. Обычно к анализам прилагается таблица с нормами. Несмотря на это, интерпретацию результатов должен осуществлять врач.
Положительный результат указывает на инфекцию, за исключением случаев, когда «плюс» на титр антител получен сразу после эрадикации микобактерии. Даже после успешного лечения антитела могут оставаться в организме и давать положительный результат. Поэтому анализы не следует сдавать сразу после эрадикации — должно пройти как минимум 30 дней. Если терапия была успешной, микроб не будет обнаружен, и уровень Helicobacter pylori в крови останется в пределах нормы.
Симптоматика хеликобактериоза
После внедрения в организм микроб начинает выделять специфический фермент, который со временем повреждает эпителий желудка. Часто хеликобактериоз протекает бессимптомно, то есть в латентной форме. Эта форма наблюдается у людей с крепким иммунитетом, но при его снижении инфекция активируется. Существуют также менее агрессивные штаммы, которые в малой степени поражают слизистую оболочку и не вызывают симптомов.
В остальных случаях у человека возникают типичные симптомы хронического гастрита:
- боль в желудке;
- тяжесть после еды;
- изжога;
- тошнота, реже рвота;
- отрыжка;
- ощущение переполненности желудка;
- неприятный привкус;
- запоры, поносы;
- боли в животе;
- вздутие живота;
- снижение аппетита.
При наличии дополнительных факторов риска (курение, алкоголизм, плохое питание, стрессы) у человека, не проходящего лечение хеликобактер пилори, могут развиваться язва желудка, поражение двенадцатиперстной кишки и эрозии желудка.
Анализ на иммуноглобулины
Хеликобактер пилори можно обнаружить в крови с помощью анализа на иммуноглобулины — специфические белки, участвующие в борьбе с инфекцией. Однако их выработка не происходит мгновенно. При наличии инфекции в организме важно определить три типа белков: М, А и G. Каждый из них выполняет свою роль в воспалительном процессе:
- М — указывает на раннее инфицирование, когда симптомы еще не проявляются. Этот маркер встречается редко, но его обнаружение может предотвратить заражение близких.
- А — свидетельствует о ранней стадии инфицирования или о явном воспалительном процессе. Его можно найти в слюне и желудочном соке. Высокий уровень иммуноглобулина А указывает на активность хеликобактер и заразность.
- G — подтверждает наличие хеликобактер пилори в организме. Этот маркер может появиться на 3-4 неделе после заражения, но его высокий уровень может сохраняться некоторое время после выздоровления.
Теперь рассмотрим преимущества и недостатки этого анализа на хеликобактер пилори.
Преимущества:
- Эффективность лабораторного исследования: иммуноглобулины G обнаруживаются в 95-100 % случаев, A — в 65-85 %, M — в 18-20 %.
- Возможность сравнения результатов с предыдущими анализами, что помогает отслеживать развитие заболевания и оценивать эффективность терапии.
- Этот метод с большей вероятностью подтверждает заражение, чем иммуноферментный анализ на антитела.
Недостатки:
- Для появления основного маркера (иммуноглобулина G) требуется почти месяц, что затрудняет раннюю диагностику и лечение.
- После полного выздоровления (особенно у пожилых пациентов) высокий титр может сохраняться до 1-1,5 лет.
- Метод не позволяет различить острую стадию инфекции и пассивное присутствие хеликобактер в желудке.
Способ бактериологического посева
Выделение культуры возбудителя — это микробиологическое исследование. Классический метод включает посев материала на питательную среду, подсчет выросших колоний и микроскопическое исследование микроорганизмов. Также проводятся биохимические пробы для изучения свойств возбудителя и дополнительный посев на среду с антибиотиками для определения чувствительности к различным препаратам.
Питательная среда для посева довольно дорогая и готовится специально.
Анализ кала на хеликобактер пилори с использованием культурального метода имеет свои сложности:
- Посев должен проходить без доступа кислорода.
- Можно выделить только спиралевидные формы, которые редко встречаются в кале, а не кокковые.
- Результаты тестов на чувствительность к антибиотикам in vitro (в пробирке) могут быть обманчивыми и не совпадать с фактической эффективностью у пациента (in vivo); оптимальный антибиотик может оказаться недостаточно эффективным.
- Анализ требует длительного времени (7–10 дней) для завершения.
По этим причинам использование данного метода для диагностики ограничено.